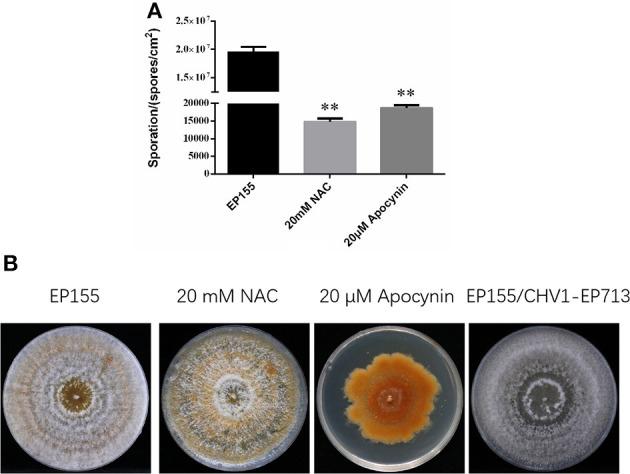
https://cdn.ncbi.nlm.nih.gov/pmc/blobs/11f5/10336323/d8ff3329585c/fmicb-14-1206603-g0004.jpg

低毒病毒感染诱导栗疫病菌中线粒体的增殖并扰乱其功能。
Hypovirus infection induces proliferation and perturbs functions of mitochondria in the chestnut blight fungus.
作者信息
Wang Jinzi, Quan Rui, He Xipu, Fu Qiang, Tian Shigen, Zhao Lijiu, Li Shuangcai, Shi Liming, Li Ru, Chen Baoshan
机构信息
State Key Laboratory for Conservation and Utilization of Subtropical Agro-Bioresources and College of Life Science and Technology, Guangxi University, Nanning, China.
Guangxi Key Laboratory for Polysaccharide Materials and Modifications, Key Laboratory of Protection and Utilization of Marine Resources, School of Marine Sciences and Biotechnology, Guangxi Minzu University, Nanning, China.
出版信息
Front Microbiol. 2023 Jun 28;14:1206603. doi: 10.3389/fmicb.2023.1206603. eCollection 2023.
INTRODUCTION
The chestnut blight fungus, , and hypovirus have been used as a model to probe the mechanism of virulence and regulation of traits important to the host fungus. Previous studies have indicated that mitochondria could be the primary target of the hypovirus.
METHODS
In this study, we report a comprehensive and comparative study comprising mitochondrion quantification, reactive oxygen species (ROS) and respiratory efficiency, and quantitative mitochondrial proteomics of the wild-type and virus-infected strains of the chestnut blight fungus.
RESULTS AND DISCUSSION
Our data show that hypovirus infection increases the total number of mitochondria, lowers the general ROS level, and increases mitochondrial respiratory efficiency. Quantification of mitochondrial proteomes revealed that a set of proteins functioning in energy metabolism and mitochondrial morphogenesis, as well as virulence, were regulated by the virus. In addition, two viral proteins, p29 and p48, were found to co-fractionate with the mitochondrial membrane and matrix. These results suggest that hypovirus perturbs the host mitochondrial functions to result in hypovirulence.
引言
栗疫病菌和低毒病毒已被用作探究毒力机制以及对宿主真菌重要性状调控的模型。先前的研究表明线粒体可能是低毒病毒的主要作用靶点。
方法
在本研究中,我们报告了一项全面的比较研究,包括对栗疫病菌野生型和病毒感染菌株进行线粒体定量、活性氧(ROS)及呼吸效率测定,以及线粒体定量蛋白质组学分析。
结果与讨论
我们的数据表明,低毒病毒感染会增加线粒体总数,降低总体ROS水平,并提高线粒体呼吸效率。线粒体蛋白质组定量分析显示,一组参与能量代谢、线粒体形态发生以及毒力的蛋白质受病毒调控。此外,发现两种病毒蛋白p29和p48与线粒体膜和基质共分离。这些结果表明,低毒病毒干扰宿主线粒体功能从而导致低毒力。